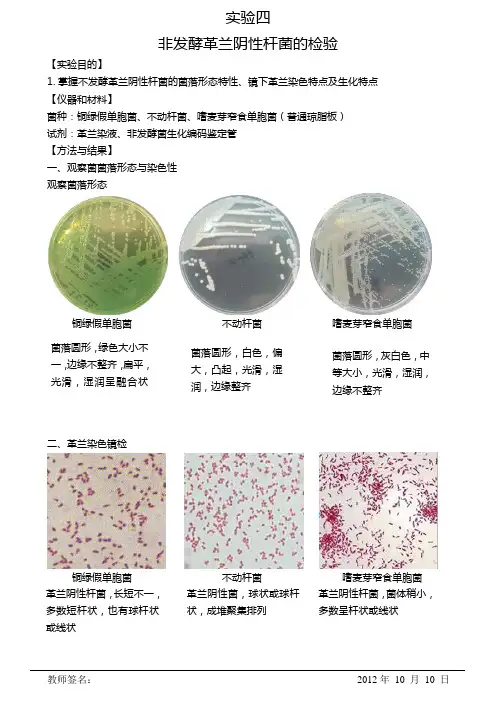
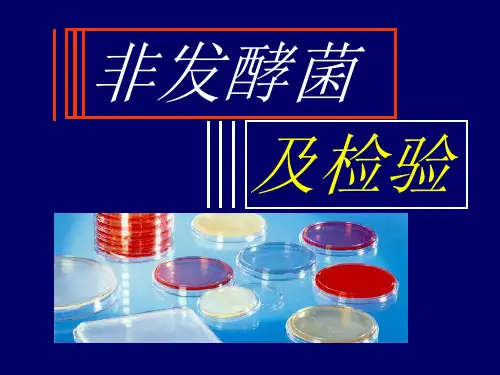

非发酵菌的鉴定
- 格式:doc
- 大小:466.50 KB
- 文档页数:7
教师签名:2012年10 月10 日实验四非发酵革兰阴性杆菌的检验【实验目的】1.掌握不发酵革兰阴性杆菌的菌落形态特性、镜下革兰染色特点及生化特点【仪器和材料】菌种:铜绿假单胞菌、不动杆菌、嗜麦芽窄食单胞菌(普通琼脂板)试剂:革兰染液、非发酵菌生化编码鉴定管【方法与结果】一、观察菌菌落形态与染色性观察菌落形态铜绿假单胞菌不动杆菌嗜麦芽窄食单胞菌二、革兰染色镜检铜绿假单胞菌不动杆菌嗜麦芽窄食单胞菌革兰阴性杆菌,长短不一,多数短杆状,也有球杆状或线状革兰阴性菌,球状或球杆状,成堆聚集排列革兰阴性杆菌,菌体稍小,多数呈杆状或线状菌落圆形,绿色大小不一,边缘不整齐,扁平,光滑,湿润呈融合状菌落圆形,白色,偏大,凸起,光滑,湿润,边缘整齐菌落圆形,灰白色,中等大小,光滑,湿润,边缘不整齐教师签名: 2012年 10 月 10 日三、生化实验1.氧化酶实验(滤纸法)铜绿假单胞菌(阳性) 不动杆菌(阴性) 嗜麦芽窄食单胞菌(阴性)2.OF 实验接种OF 半固体2支(其中闭管一支加无菌液体石蜡,开管则不加)+石蜡未+石蜡 三种菌都是未加石蜡的变黄,加石蜡的不变黄,说明三种菌都在氧气参与时分解葡萄糖。
铜绿假单胞菌、不动杆菌、嗜麦芽窄食单胞菌都为:氧化型3.接种微量生化管【讨论】1. 本次实验的三种非发酵菌革兰染色均为阴性,不易区分,主要靠生化实验来鉴别。
2. 氧化酶实验中,应特别注意挑完绿脓杆菌的接种环应绝对严格烧灼灭菌,否则会造成不动杆菌和嗜麦芽窄食单胞菌的假阳性出现。
或先检验不动杆菌和嗜麦芽窄食单胞菌,最后检验绿脓杆菌,也可避免绿脓杆菌对另外两种菌的影响。
3. OF 实验中,由于嗜麦芽窄食单胞菌对葡萄糖氧化不明显,过夜培养可成中性或弱碱性,黄色很不明显,可继续培养至48小时后呈酸性,见明显黄色出现。
4. 铜绿假单胞菌普通培养可见菌落和培养基都呈绿色,说明该菌课产生绿色色素,并分泌至胞外,色素为水溶性色素,区别于金黄色葡萄球菌的脂溶性色素,金葡菌的脂溶性色素之表现为菌落黄色,培养基不变色。

每日一菌之非发酵菌及检验一、概述非发酵菌主要是指一群①不发酵或不分解糖类的②革兰阴性③无芽胞④需氧杆菌。
目前,非发酵菌包括13个属。
主要有假单胞菌属、不动杆菌属、产碱杆菌属、莫拉菌属、黄杆菌属等。
这些细菌大多为条件致病菌。
对于非发酵菌的鉴定,必须首先进行种属间的鉴别,然后进行种间的鉴定。
一般实验室只需用几项试验,如氧化酶、O-F试验、动力及鞭毛、菌落色素、硝酸盐还原试验以及在麦康凯琼脂上的生长情况等即可对90%~95%分离的菌株作出初步鉴定。
1.培养温度:多数非发酵菌适宜生存于自然界,培养温度以30℃为宜。
有的更适宜生长于室温(18℃~22℃)。
故常规标本应先培养于35℃~37℃,再培养于30℃或室温。
2.动力与鞭毛:在非发酵菌的鉴定中,细菌是否具有鞭毛及鞭毛的特点有重要的诊断意义。
由于非发酵菌大部分为专性需氧菌,在半固体培养基上观察动力不明显,因细菌在琼脂表面生长,底层穿刺生长不良或不生长,故观察非发酵菌的动力以30℃或室温12~24h培养物悬滴法为准。
有时需借助鞭毛染色予以鉴定。
3.氧化酶试验:该试验是鉴定非发酵菌的重要试验,非发酵菌中除不动杆菌、嗜麦芽窄食单胞菌及个别假单胞菌外,氧化酶试验均为阳性。
4.氧化-发酵(O-F)试验:本试验是确定非发酵菌与发酵菌以及测定非发酵菌是否利用糖的基本试验。
非发酵菌对葡萄糖的代谢特点是氧化型产生微量酸。
在氧化-发酵(O-F)试验中,应为开管产酸,闭管不变。
5.在麦康凯琼脂上生长情况:如假单胞菌属、不动杆菌属、产碱杆菌属等生长,而莫拉菌属和艾肯菌属等不生长。
非发酵菌几种主要菌属的基本特征见表5-25-1。
表5-25-1 非发醇菌主要菌属的基本特征二、假单胞菌属假单胞菌属为一大组革兰阴性杆菌,大量存在于水、土壤和空气中。
在人类感染的非发酵菌中,假单胞菌属约占70%~80%,主要为铜绿假单胞菌(约55%~65%)。
其次为嗜麦芽窄食单胞菌、荧光假单胞菌、恶臭假单胞菌、产碱假单胞菌等。
⾮发酵菌微⽣物学检验⾮发酵G-杆菌(nonfermentative G- Bacilli)1. ⾮发酵菌是⼀群需氧、⽆芽孢、不利⽤糖或仅能氧化分解糖类是做为能量来源的G-杆菌。
(1)通常所讲的⾮发酵菌指在KIA中24⼩时内表⾯能够⽣长,在底部不⽣长的需氧G-杆菌。
(2)⾮发酵菌与其它苛养或⾮糖发酵的G-杆菌之间的界限只是传统意义上的,并不是根据明确的遗传或表型特点来划分。
(3)多为条件致病菌,近年来⽇益增多,尤其是医院感染。
2. 分类与命名:主要的⾮发酵G-杆菌属被分成6个科:(1)假单胞菌科:根据rRNA-DNA同源性分为5个rRNA群①rRNAⅠ群/假单胞菌属;②rRNAⅡ群/伯克霍尔德菌属;③rRNAⅢ群/丛⽑单胞菌属、⾷酸菌属;④rRNAⅣ群/短波⽑单胞菌属;⑤rRNAⅤ群/窄⾷单胞菌属;⑥其它:鞘氨醇单胞菌属、希⽡菌属等(2)产碱杆菌科:产碱杆菌属;(3)黄杆菌科:华丽杆菌属(4)莫拉菌科:不动杆菌属、莫拉菌属;(5)甲基球菌科;(6)根瘤菌科3. ⾮发酵菌的基本鉴定要求(1)缺少糖发酵的证据,通常是在KIA或TSI培养基中⽆酸产⽣,斜⾯和底部均呈红⾊。
(2)氧化酶+(不动杆菌、嗜麦芽窄⾷单胞菌、唐菖蒲伯克菌、浅黄华丽单胞菌、栖稻黄素单胞菌-),但并⾮所有氧化酶+的G-杆菌都是⾮发酵菌。
(3)麦康凯上⽣长很差或不⽣长。
(4)动⼒:多为+,但多为专性需氧,故半固体培养基中不明显,宜⽤直接动⼒观察或染⾊法。
4. 重要的鉴定试验(1)葡萄糖利⽤(O/F试验):O/F培养基:蛋⽩胨和糖类的⽐例为1:5⽽不同于发酵菌的1:2。
(2)氧化酶试验:(3)动⼒:半固体培养基:应只穿刺培养基顶部4mm,在培养4-6⼩时后⾸次观察结果,24和48⼩时后再次观察结果。
更准确的⽅法是湿⽚法和鞭⽑染⾊。
(4)⾊素形成:⾮发酵菌可形成多种⾊素,有助于菌种的鉴定。
(5)硝酸盐还原/产⽓:将硝酸盐还原成亚硝酸盐,进⽽释放氮的⽣化过程。
非发酵菌的鉴定
定义:非发酵菌(nonfermenters)指一群需氧或兼性厌氧、不发酵糖类,能在普通培养基上生长的革兰阴性杆菌。
主要存在外界环境中,种类繁多,多为条件致病菌或医院内感染菌。
关于临床标本中NFB的意义,在混合培养物中见到时,必须考虑到患者的情况和标本来源。
一般来说,以纯培养方式分离自正常无菌部位的NFB,一定要鉴定到种并进行抗生素敏感性试验。
目前CLSI中,K-B法除了假单胞菌属、不动杆菌属、嗜麦芽窄食单胞菌和洋葱伯克霍尔德菌有抗生素敏感性实验的判断标准外,其他非发酵菌没有K-B法的标准。
一、鉴定原则:
1.血、无菌部位(脑脊液、胸水等),特殊病人,少见菌可用API-20NE或VIKET TWO-GN 卡鉴定。
2.其它部位如呼吸道标本、临床常见的非发酵,根据菌落形态、生化反应、抗生素耐药谱等综合分析手工法鉴定即可。
二、非发酵性菌基本分类:
假单胞菌属Pseudomonas spp.(20多个临床上重要菌种中,铜绿假单胞菌、荧光假单胞菌和恶臭假单胞菌等最常见。
)
不动杆菌属Acinetoacter spp.(最常分离的种鲍曼不动杆菌、鲁氏不动杆菌、溶血不动杆菌等)
窄食单胞菌Stenotrophomonas spp.(嗜麦芽窄食单胞菌、非洲嗜麦芽窄食单胞菌)
伯克霍尔德菌Burkholderia spp.(洋葱伯克霍尔德菌、唐菖蒲伯克霍尔德菌、类鼻疽伯克霍尔德菌等)
鞘氨醇单胞菌属Sphingomonas spp.(少动鞘氨醇杆菌)
无色杆菌属Achromobacter spp.(木糖氧化无色杆菌)
希瓦氏菌属Shewanella spp. (腐败希瓦氏菌海藻希瓦氏菌)
产硷菌属Alcaligenes spp.
黄杆菌属Flavoacterium spp.
莫拉菌属Moraxella spp.
罗尔斯通菌属 Ralstonia spp.
食酸菌属Acidovorax spp.
丛毛单胞菌属Comamonas spp.
甲基杆菌属Methylobacterium spp.
等还有一些未定名的菌群
三、辨认非发酵菌的基本要点
1. 分离培养基上的菌落有以下情况初步考虑非发酵菌的存在
a.培养基上生长较差或中国蓝上不生长的阴性菌。
(如艾肯菌属、心杆菌属、金氏杆菌属)
b.中国蓝平板上为不发酵乳糖的菌落,氧化酶阳性的高度怀疑非发酵菌。
但并非所有的氧化酶阳性的均为非发酵菌。
如弧菌属、气单胞菌属、邻单胞菌属、巴斯德菌属等。
c.革兰阴性菌在三糖管上培养,底层和斜面均不变色,疑为非发酵菌。
但容易受影响。
2. 葡萄糖的利用大部分非发酵菌生长缓慢产生弱酸,而蛋白胨形成的产物即可升高培养基的PH值,中和非发酵菌产生的弱酸性产物。
根据他的代谢特点,用氧化-发酵培养基鉴别分类该类菌。
附:氧化-发酵葡萄糖培养基(O-F培养基)配方
成分: 蛋白胨 0.8g 氯化钠 2.0g
三水磷酸氢二钾 0.15g 葡萄糖 4.0g
琼脂 1.1g 蒸馏水 400.0ml
方法: 热溶, 调PH7.1, 加入1%溴麝香草酚兰酒精溶液1.2ml分装,
8磅15分钟, 备用.
*(O-F培养基)蛋白胨与糖类比为0.2:1
实验室中根据氧化发酵葡萄糖的情况
发酵葡萄糖发酵菌肠杆菌科
弧菌科
非发酵菌氧化型
非氧化型
3.动力:鉴别分类的依据
动力阳性的非发酵菌主要有:
假单胞菌属、窄食单胞菌、伯克霍尔德菌、无色杆菌属、希瓦氏菌属、产硷菌属、鞘氨醇单胞菌属(18-22℃)甲基杆菌属等
动力阴性的非发酵菌主要有:
不动杆菌属、黄杆菌属、莫拉菌属等
4.氧化酶试验:细胞色素氧化酶的产生与否鉴别分类
氧化酶试验阳性的非发酵菌主要有:假单胞菌属、伯克霍尔德菌、无色杆菌属、希瓦氏菌属、黄杆菌属、莫拉菌属等
氧化酶试验阴性的非发酵菌主要有:不动杆菌属、窄食单胞菌等
5.在中国兰上生长能力:一般在35℃24小时生长良好,但有些需要35℃24小时后在室温或30℃继续培养24小时。
6.色素:(常见菌)
产黄色素的有:洋葱伯克霍尔德菌、唐菖蒲伯克霍尔德菌、嗜麦芽窄食单胞菌、金黄杆菌属、少动鞘氨醇单胞菌属等;
产蓝绿色素的有:Pae
产荧光色素的有:Pae、恶臭假单胞菌、荧光假单胞菌;
产紫色色素的有:紫色色杆菌
产红棕色或淡紫色的有:腐败希瓦氏菌
四、实验室鉴定临床常见的非发酵菌
根据菌落形态、生化反应和抗生素耐药谱鉴定临床常见非发酵菌。
(一)铜绿假单胞菌
目前临床分离率最高的非发酵菌.
•天然耐多种抗生素.
•易在呼吸道定植
•菌落特征有三种
典型菌落,黏液性菌落,粗造型菌落,侏儒型菌落
鉴定要点:
葡萄糖氧化型菌、氧化酶阳性、动力阳性,典型菌落为圆形、边缘呈伞状伸展、扁平湿润、有金属光泽、有特殊味道的棕色或绿色的菌落。
铜绿假单胞菌与产生荧光菌群的主要区别
单鞭毛丛鞭毛水解明胶42℃生长
铜绿假单胞菌+ - -/+ +
荧光假单胞菌- + + -
恶臭假单胞菌- + - -
(二)不动杆菌
不动杆菌属:(最常分离的种为鲍曼不动杆菌、鲁氏不动杆菌、溶血不动杆菌等)鉴定要点:
葡萄糖氧化型菌、氧化酶阴性、无动力,菌落为圆形、隆起、光滑边缘整齐、在中国兰上呈兰色或粉白色,硝酸盐阴性。
鲍曼不动杆菌与其它常见不动杆菌的主要区别
生长
溶血CIT丙二酸盐葡萄糖乳糖明胶44℃41℃37℃
鲍曼不动杆菌+ + + - + + + + - 溶血不动杆菌- - + + + - +/- - + 琼氏不动杆菌- + + - +/- - - + - 洛菲不动杆菌- - + - - - - - -
(三)嗜麦芽窄食单胞菌(曾用名嗜麦芽假单胞菌、嗜麦芽黄单胞菌)
是重要的医院获得性感染病原体,临床感染大部分都是医院感染。
鉴定要点:
1.菌落形态特点:呼吸道标本为主,中国兰上小、光滑湿润,血平板上有黄色色素。
2.生化反应:革兰阴性非发酵菌,氧化酶阴性,赖氨酸和DNA酶阳性,有动力,可快速氧化分解麦芽糖,。
3.耐药表型:多重耐药、天然耐亚胺培南,70-80%对复方新诺明有体外活性。
(四)洋葱伯克霍尔德菌
鉴定要点:
菌落形态特点:最适生长温度30℃,有些菌株在35℃生长较差、在含有铁离子培养基(三糖铁琼脂)中黄色色素较明显。
生化反应:革兰阴性非发酵菌,氧化酶阳性,赖氨酸脱羧酶阳性,有动力,过氧化氢反应迟缓。
耐药表型:多重耐药、天然耐亚胺培南,对复方新诺明有体外活性。
洋葱伯克霍尔德菌与其他伯克霍尔德菌的主要区别
氧化酶ONPG
硝酸盐
精氨酸赖氨酸皱缩形菌落还原产气
类鼻疽伯克霍尔德菌+ - + + + - +
洋葱伯克霍尔德菌+ V V - - + -
唐菖蒲伯克霍尔德菌- + V - - - -
注意:类鼻疽伯克霍尔德菌有刺激性泥土味,可通过呼吸道传播,实验室工作人员在鉴定时应注意安全;它的生长有特定的生态区域,存在于赤道南北纬20℃之间的土壤和不流动的水中,主要在泰国和越南。
实验室报告时应慎重。
(五)希瓦氏菌属
希瓦氏菌属包括腐败希瓦氏菌、海藻希瓦氏菌两种。
鉴定要点:
菌落形态特点:圆形、凸起光滑的菌落、偶尔为黏液性、产生黄褐色色素。
生化反应:革兰阴性非发酵菌,氧化酶阳性,在三糖铁中产生H2S ,是非发酵菌中唯一产H2S的菌。
腐败希瓦氏菌和海藻希瓦氏菌的主要区别.
蔗糖麦芽糖葡萄糖核糖 6.5%NaCl42℃生长来源腐败希瓦氏菌+ + V - - - 牛奶,鱼海藻希瓦氏菌- - - V + + 人
注意:临床中从人类分离的该菌属以海藻希瓦氏菌为主(77%),但临床中分离到的腐败希瓦氏菌多与感染有关。
五、API 20 NE 介绍
非肠道革兰阴性杆菌鉴定系统可鉴定假单胞菌属、不动杆菌属、黄杆菌属、无色杆菌属、产硷杆菌属、土壤杆菌属、色杆菌属、窄食单胞菌、伯克霍尔德菌属、莫拉菌属、黄单胞菌属、博德特菌属和巴斯德菌属等。
标准鉴定系统,包括8个标准化常规测试和12个同化试验。
六、非发酵菌鉴定双歧索引
参考书籍
1.Diagnostic Microbiology
2.Manual of Clinical Microbiology 第7版3. 临床微生物学诊断与图解
4.API说明书。